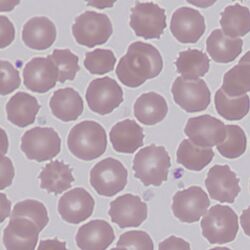
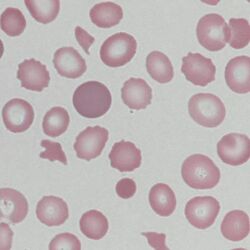

Echinocytes
From haematologyetc.co.uk
(Also known as burr cells)
Derivation: the Greek echinis [hedgehog]
Appearance
Mature echinocytes have 10-30 surface projections. These tend to be short, blunt, and are distributed relatively evenly across the cell. The appearances develop over time so there is a spectrum of forms. The cells initially resemble normal erythrocytes with subtle projections, these projections become increasingly clear in the mature echinocyte. Depending on the cause a late stage may be found where the cell body becomes dense and the projections become more spike-like.
Images There are short, blunt projections distributed (relatively) evenly across the erythrocyte surface. The projections arise in three dimensions on the cell so when flattened may sometimes be seen as dark patches on the erythrocyte surface (as shown here). More frequently the projections appear only around the edge of the cells (see clinical images). In the end-stage of their development severely damaged forms are produced that have a dense and contracted cell body (sphero-echinocytes). Otherwise, these cells tend to have normal size and retain central pallor. Often, they are the only abnormal form present, although depending on the underlying cause (see table) other features may be found.
Significance
Always remember that echinocytes may be an artefact of blood storage or of poor film preparation (artefactual echinocytosis) so look at the condition of other cells on the film and determine whether the echinocytosis is patchy in distribution. Where genuine there will usually be a significant systemic disease present. This most frequently will be renal failure, but see "causes".
Pitfalls
Echinocytes should be distinguished from acanthocytes which have fewer, longer and more irregularly distributed projections.
Causes
| Artefact |
|---|
| Prolonged storage of sample before spreading |
| Glass/Ph effect |
| Slow drying |
| Energy depletion |
| Pyruvate kinase deficiency (note that the cells also resemble acanthocytes – the abnormal forms being prominent only after splenectomy). See Clinical Image. |
| Altered hydration |
| Renal failure |
| Electrolyte imbalance |
| Diuretic treatment |
| Altered membrane composition |
| Drugs (doxorubicin) |
| Snake venom |
Clinical Examples
Clinical Image 1 A very nicely formed echinocyte whose 3-D spicules can be appreciated across the surface as well as the perimeter of the cell. There are other abnormalities here most obviously the teardrop poikilocytes and fragments. Clinical disorder: myelofibrosis.
Clinical Image 2: Echinocytes at a range of different developmental stages from almost normal through to dense and contracted – in this case an artefact of a poorly fixed slide. Clinical disorder: none (artefact).
Clinical Image 3: Echinocytes, fragmented erythrocyte forms, polychomasia and microspherocytes are present; platelets are absent. Clinical disorder: thrombotic thrombocytopenic purpura with accompanying renal failure.
Pathobiology
Echinocytes most frequently reflect electrolyte disturbance arising from altered membrane permeability or from metabolic disturbance that impairs electrolyte pumping (this contrasts with acanthocytes which arise from lipid abnormality). Early forms of the echinocyte are fully reversible, but the "spheroechinocyte" is an irreversible final stage.